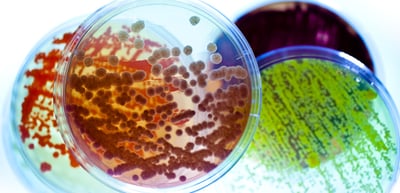

News and stories
We open our treasure chest
Where our enzymes originate
In our enzyme engineering technology, everything starts with identifying the right enzyme. Nature offers an almost inexhaustible source for identifying new enzymes. In one gram of soil there can be billions of bacteria, thousands of different microorganisms, all of which have very different properties. These can be used in industry to develop or improve products and processes. The best thing about it is: even the smallest amounts of environmental samples are enough to identify suitable candidates, which can then be further developed into enzyme products.

c-LEcta's treasure chests currently contain around 10,000 strains from a wide variety of biotopes, which offer a very diverse portfolio of enzymes. Microorganisms can be found almost everywhere - even in extreme locations such as the Arctic or hot springs. Such locations can be interesting when looking for enzymes that work under such extreme conditions. But you don't have to travel far to find exciting microorganisms with high diversity. “You can take microbes from soil samples right on our doorstep,” reports Dr. Rico Czaja, Head of Enzyme Discovery and Bioprospecting at c-LEcta. “And if you go just a few steps further, the composition of the microbial community can look completely different.”
 c-LEcta's environmental samples come from a wide variety of sources, e.g. from baby diapers, sheep's tripe, soil samples or water. In collaboration with the University of Leipzig, for example, samples from treetops in the Leipzig riparian forest were analyzed. There can be very strong temperature differences between day and night, and high UV exposure, due to direct sunlight, resulting in occurance of very robust bacteria. Another project looked at samples of contaminated industrial soil and aimed to investigate whether these contaminations could be broken down using enzymes. Further, material of very unusual origin came from the grease trap in the cafeteria at the University of Leipzig.
c-LEcta's environmental samples come from a wide variety of sources, e.g. from baby diapers, sheep's tripe, soil samples or water. In collaboration with the University of Leipzig, for example, samples from treetops in the Leipzig riparian forest were analyzed. There can be very strong temperature differences between day and night, and high UV exposure, due to direct sunlight, resulting in occurance of very robust bacteria. Another project looked at samples of contaminated industrial soil and aimed to investigate whether these contaminations could be broken down using enzymes. Further, material of very unusual origin came from the grease trap in the cafeteria at the University of Leipzig.
What happens next: Once the samples have been collected, the next step is to extract the DNA of the microorganisms, because the enzymes are encoded there as genetic information. Unfortunately, only very few microorganisms can be cultivated and enriched in the laboratory. In order to be able to exploit the genetic treasure of these uncultivable microorganisms, simply all of the DNA present in the environmental sample is extracted to obtain its so-called metagenome.
The information encoded in the genomes or metagenomes must next be translated into enzymes so that their properties can be analyzed. Since the genetic code is almost identical in all living things, fragments of genomic or metagenomic DNA can be introduced into special production bacteria, which then produce the enzymes. These bacteria, with all the inserted fragments of a genome or metagenome are called libraries. The libraries are then stored and can be screened again and again for enzymes.
The information encoded in the genomes or metagenomes must next be translated into enzymes so that their properties can be analyzed. Since the genetic code is almost identical in all living things, fragments of genomic or metagenomic DNA can be introduced into special production bacteria, which then produce the enzymes. These bacteria, with all the inserted fragments of a genome or metagenome are called libraries. The libraries are then stored and can be screened again and again for enzymes.
The libraries are ultimately stored at -150°C in special freezers and can thus be preserved almost indefinitely.
